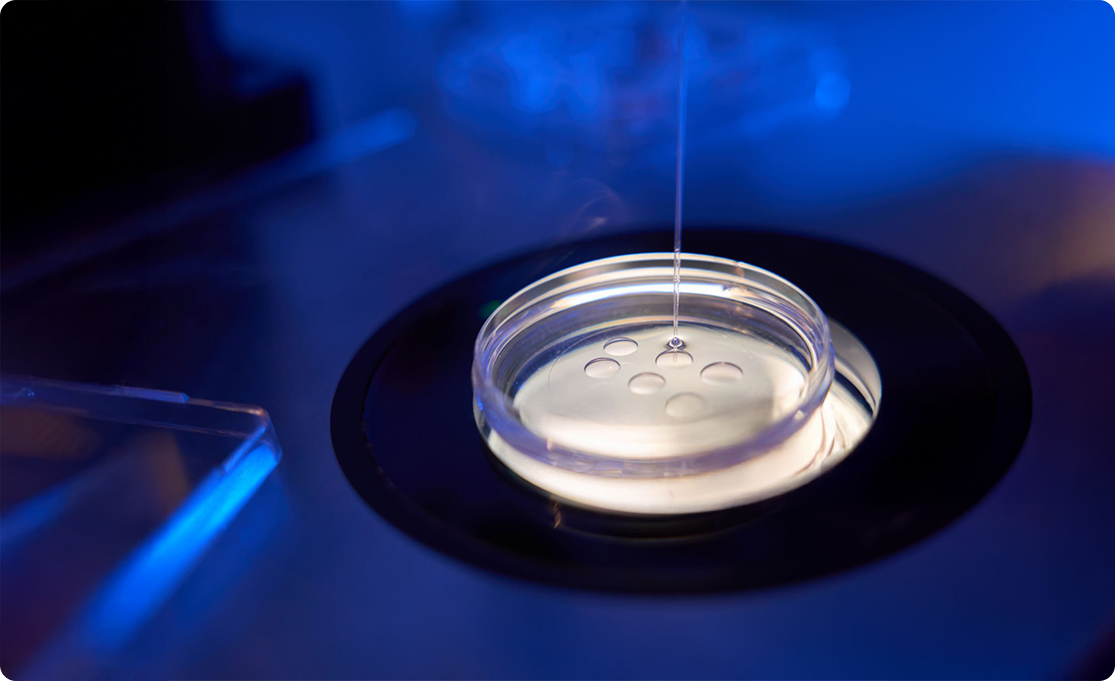
Advanced Vitrification

Home›Treatments›Advanced Treatment ›Advanced Technology - Cryopreservation
Cryopreservation of Human Gametes
Why Cryopreservation Is Important in Fertility Care
What It Is
Cryopreservation freezes sperm or eggs at ultra-low temperatures for future use.
Why It's Needed
The gametes are cooled using advanced vitrification methods that prevent ice formation, maintaining their structure and viability for years.
Why It’s Done
Ideal for individuals or couples who want to delay pregnancy, preserve fertility before medical treatments, or use donor gametes later.
Who It Helps
Men with low sperm counts, women with limited egg reserve, or couples undergoing IVF who wish to save embryos for future cycles.
Result
Cryopreserved samples retain their fertility potential even after thawing — offering flexibility, reassurance, and hope.
Added Advantage
A proven, safe, and effective method for preserving reproductive cells without compromising quality or success rates.
Preserving fertility safely, effectively, and for longer.
Advanced Vitrification
Rapid freezing prevents ice formation and preserves cell integrity.
Safely freezing life for future possibilities.
Gamete Collection
Eggs or sperm are collected and evaluated for quality before freezing.
Vitrification (Freezing)
Gametes are rapidly frozen using cryoprotectants to prevent ice damage.
Storage & Preservation
Samples are stored in liquid nitrogen at -196°C, maintaining viability for years.
Thawing & Quality Assessment
When ready, samples are carefully thawed and assessed for quality before being used in IVF or other fertility treatments.
98%
post-thaw viability ensures cryopreserved eggs, sperm, and embryos retain quality for successful future IVF outcomes.
Inspiring stories of strength & Victories
Your dream of parenthood deserves the best. Our specialists offer advanced fertility treatments for higher success.


